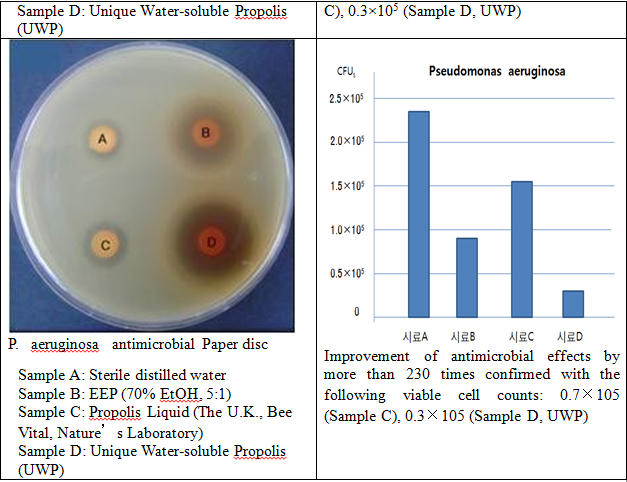
Nghi&ecirc;n cứu Unique Biotech. Co., ltd về khả năng ức chế sự ph&aacute;t triển vi khuẩn E.Coli v&agrave; P. aeruginosa antimicrobial

Keo ong - 6 lợi ích hàng đầu và cách dùng hiệu quả
Keo ong được sử dụng phổ biến ở nhiều nước trên thế giới song ở Việt Nam còn nhiều người chưa quen thuộc sản phẩm này. Keo ong được biết đến nhiều như một nguyên liệu kháng sinh tự nhiên lành tính nhưng còn rất nhiều các tác dụng hữu ích khác của nguyên liệu thiên nhiên này đã được các nhà khoa học khám phá và công bố.
Tin nên đọc




Keo ong là gì?
Dưới góc độ khoa học, keo ong (Propolis) là một hỗn hợp rất phức tạp gồm nhựa từ các chồi cây, hoa được ong mật thu thập, kết hợp với nước bọt của ong mà thành. Keo ong có dải màu từ nâu đến xanh lục đậm, phụ thuộc vào nguồn thực vật mà ong mật thu thập được.
Chất keo này được loài ong sử dụng giống như xi măng để xây, gia cố, ổn định cấu trúc tổ, giảm rung, sửa chữa những vết rách, lấp các kẽ hở không mong muốn và tăng cường phòng thủ.
Chất keo này cũng được những chú ong thợ cần mẫn sử dụng để làm tổ cho ong chúa trước khi đẻ, nhằm ngăn ngừa ký sinh trùng, hạn chế sự phát triển của vi khuẩn, nấm mốc, phòng chống sự thối rữa và mọi khả năng lây lan các bệnh gây hại tới các “thành viên mới” trong tổ.

Hiện nay có hơn 1800 nghiên cứu khoa học được Trung tâm thông tin quốc gia của Mỹ về công nghệ sinh học và sức khỏe (The National Center for Biotechnology Information - http://www.ncbi.nlm.nih.gov/ ), Thư viện thuốc quốc gia của Mỹ (U.S. National Library of Medicine - http://www.nlm.nih.gov/ ) và Viện nghiên cứu sức khỏe quốc gia của Mỹ (National Institutes of Health - http://www.nih.gov/ ) nghiên cứu về thành phần và công dụng mà keo ong mang lại.
Thật bất ngờ khi các nhà nghiên cứu xác định được rằng có tới hơn 300 hợp chất hóa học có trong keo ong, chủ yếu là polyphenol (chất có đặc tính chống oxy hóa giúp chống lại việc tạo lập các gốc tự do dư thừa trong cơ thể).
Các polyphenol chính có trong keo ong là flavonoids, kèm theo axit phenolic và este, andehit phenolic, ketones... Ngoài ra, trong keo ong còn có các nguyên tố cần thiết như magiê, nickel, canxi, sắt và kẽm. Các hợp chất này bao gồm dầu dễ bay hơi, các axit thơm (5-10%), các loại sáp (30-40%).
Tùy theo khu vực địa lý và nguồn gốc của loài ong, thành phần hóa học trong keo ong sẽ thay đổi. Trong mẫu keo ong từ Brazil và Trung Quốc có thêm hợp chất mới là axit 3,5- diprenyl-4-hydroxycinnamic và octacosanol.

Vai trò của keo ong với sức khỏe con người
Từ xa xưa, người Ai Cập đã biết rất rõ các đặc tính của keo ong và đã sử dụng nó cho việc chữa bệnh. Những thầy thuốc thời đại Hy Lạp, La Mã nổi tiếng như Aristoteles, Dioscorides, Pliny và Galen đã công nhận dược tính của keo ong. Hay các thầy thuốc Ả Rập sử dụng như một chất khử trùng điều trị vết thương và làm thuốc sát trùng miệng.
Nền văn minh Inca cũng sử dụng keo ong như một phương thuốc hạ sốt. Đến thế kỷ 17, keo ong được xếp vào kho dược phẩm Luân Đôn như một loại thuốc chính thống. Giữa thế kỷ 17 đến thế kỷ 20, keo ong đã trở thành 1 loại thuốc rất phổ biến ở châu Âu vì khả năng tăng đề kháng của nó.
Kháng sinh tự nhiên
Trong y học cổ truyền, keo ong được dùng với tên thuốc là “phong giao”, có vị nhạt, tính bình, có tác dụng sát khuẩn mạnh. Y học hiện đại coi keo ong là “Liều thuốc kháng sinh tự nhiên hoàn hảo nhất” bởi qua nhiều nghiên cứu, các nhà khoa học đã chứng minh keo ong có tác dụng tương đương sự phối hợp 4 loại kháng sinh là Penicilline, Streptomycine, Neomycine và Tetracyclline.
Khả năng kháng sinh của keo ong chủ yếu dựa vào các hợp chất flavonoid pinocembrin, galangin và pinobanksin. Đây là những hợp chất có khả năng chống nấm hiệu quả. Prenylated p-coumaric và axit diterpenic có thể chống lại các vi khuẩn và các các hoạt động gây độc tế bào.
Dẫn xuất của acid Caffeoylquinic giúp điều hòa hệ miễn dịch, hepatoprotective và lignans furofuran có khả năng ức chế sự tăng trưởng của một số loại vi khuẩn.
Chính vì tác dụng này, có thể xem Keo Ong như là chất kháng sinh tự nhiên có thể được xem xét để thay thế việc dùng kháng sinh tổng hợp hiện nay dễ gây lờn thuốc khi dùng dài ngày.
Chống viêm
Keo ong với các thành phần chính bao gồm hỗn hợp như (Quercetin, artepillin-c, cinnamic acid, coumaric acid, caffeic acid..) có tác dụng kích thích sản xuất cytokine chống viêm, đặc biệt là chống viêm trực tiếp tại các vị trí bị tổn thương, kích thích tạo tế bào mới. Vì vậy, sản phẩm này có khả năng phòng chống viêm họng, viêm lợi, viêm xoang, viêm mũi, viêm mũi dị ứng, ho, cảm lạnh, cảm cúm, viêm hô hấp trên…
Tác dụng tăng cường sức khỏe, nâng cao sức đề kháng
Keo ong có thành phần hoạt chất quý là Artepillin C có rất nhiều tác dụng trong việc nâng cao khả năng miễn dịch và tự điều trị bệnh của cơ thể. Keo ong còn chứa nhiều thành phần dinh dưỡng như: sắt, đồng, kẽm, magiê, acid amin, vitamin A, các loại vitamin B, vitamin C, vitamin E, khoáng chất v.v...
Hoạt chất Flavonoid có trong keo ong chứa nhiều loại thành phần thực vật, trong đó phải kể tới tới 20 đến 30 loại hợp chất tự nhiên từ thực vật có tác dụng bổ sung dưỡng chất, vi chất có tác dung nâng cao khả năng miễn dịch của cơ thể.
Ngăn ngừa ung thư
Keo ong có chứa flavonoids, hợp chất phenol, tecpen, polysaccharides, acid hữu cơ và các chất tự nhiên khác giúp ức chế đáng kể các tế bào ung thư.
Các bệnh nhân ung thư sử dụng keo ong thường xuyên không chỉ ngăn chặn được sự di căn của tế bào ung thư, giảm tác dụng phụ do quá trình hóa trị và xạ trị gây nên mà còn từng bước nâng cao thể lực, tăng lượng bạch cầu trong máu.
Chống lão hóa
Các flavonoids trong keo ong có tác dụng bắt giữ các gốc tự do. Keo ong còn giúp kéo dài đời sống của tế bào lành, làm giảm các chứng và bệnh liên quan đến gốc tự do, vì vậy có tác dụng chống lão hóa và các bệnh do lão hóa gây ra.
Cải thiện chức năng tiêu hóa
Theo nghiên cứu của Grange và Davey (1990): Ở liều lượng 3mg/ml, keo ong có hoạt tính tích cực đối với cầu khuẩn và vi khuẩn Gram+ và ức chế sự tăng trưởng của Staphylococcus aureus, Staph. epidermidis, Enterococcus spp., Corynebacterium spp., Branhamella catarrhalis và Bacillus cereus.
Nó cũng tham gia ức chế một phần sự tăng trưởng của Pseudomonas aeruginosa và E.coli. Họ còn cho rằng, galangin và caffeic acid phenetyl ester trong chiết xuất keo ong là những nguồn chính của hiệu ứng nói trên.
Ngoài ra, keo ong giúp giảm thiểu nguy cơ viêm loét dạ dày tá tràng do ức chế vi khuẩn Helicobacter pylori, nó có chất bảo vệ, thúc đẩy và phục hồi tái sinh các tổ chức bị tổn thương, khôi phục lại khả năng tồn tại của tế bào gốc, giúp nhanh chóng phục hồi các mô và chữa các bệnh về viêm loét. Đặc biệt, keo ong chứa nhiều enzyme có tác dụng cải thiện chức năng tiêu hóa.
Những trường hợp nào cần sử dụng thận trọng keo ong?
Những người bị dị ứng với mật ong, phấn ong, sữa ong chúa, cây lá kim hoặc cây dương không nên sử dụng keo ong trừ khi đã được kiểm tra phản ứng dị ứng.
Keo ong có thể làm chậm quá trình đông máu nên có thể làm tăng nguy cơ chảy máu ở những người dùng thuốc làm loãng máu hoặc bị rối loạn chảy máu. Với người chuẩn bị trải qua ca phẫu thuật, cần ngưng sử dụng keo ong trước tối thiểu 2 tuần.
Không nên sử dụng keo ong như là phương pháp điều trị duy nhất trong nhiễm khuẩn Giardia mà không hỏi ý kiến bác sĩ trước.
Một số ý kiến cho rằng không nên dùng keo ong khi bị hen suyễn vì có thể trong keo ong có chứa một số chất làm tình trạng hen suyễn nặng hơn. Tuy nhiên, cũng đã có nghiên cứu chứng minh tác dụng có lợi của keo ong đối với bệnh hen. Vì vậy, trong trường hợp bị hen, tham khảo ý kiến bác sỹ trước khi dùng.
Cách sử dụng các dạng keo ong?
Việc chiết xuất keo ong ứng dụng sử dụng trong thực tế cũng có nhiều cách thức và dạng khác nhau: dạng viên, dạng nước, dạng xịt… Dạng bào chế quyết định đến sinh khả dụng (bioavailability) của thuốc đối với cơ thể. Các dạng uống đa số giúp thuốc hấp thu toàn thân nên có hiệu quả trong trường hợp cần tác dụng chống oxy hóa, tăng cường miễn dịch và cải thiện hệ tiêu hóa…
Đối với các trường hợp cần tác dụng tại chỗ thì dạng uống kém hiệu hơn so với dạng xịt (spray). Thí dụ trong trường hợp bị viêm họng, với 1 lần xịt (1 nhát) keo ong tại chỗ, hiệu quả điều trị và hiệu quả kinh tế sẽ ưu việt hơn so với dạng dung dịch hoặc dạng viên uống.
Nếu cần tác dụng ngoài da, có thể dùng dạng kem bôi hoặc thuốc mỡ.
Trong mỗi lọ keo ong đang lưu hành trên thị trường, người tiêu dùng cũng cần lưu ý tới hàm lượng keo ong thực sự có trong mỗi chai (lọ ). Tỷ lệ keo ong càng cao thì khả năng điều trị hỗ trợ bệnh càng tốt và việc chiết xuất keo ong với tỷ lệ cao cũng không phải là điều đơn giản mà bất kỳ hãng dược nào cũng làm được.
Hiện nay trên thị trường xuất hiện khá nhiều sản phẩm Keo ong, để đảm bảo an toàn về nhiều mặt, chúng ta nên sử dụng các sản phẩm được nhập khẩu chính ngạch từ các nước tiên tiến và có giấy chứng nhận an toàn của Bộ Y tế.


